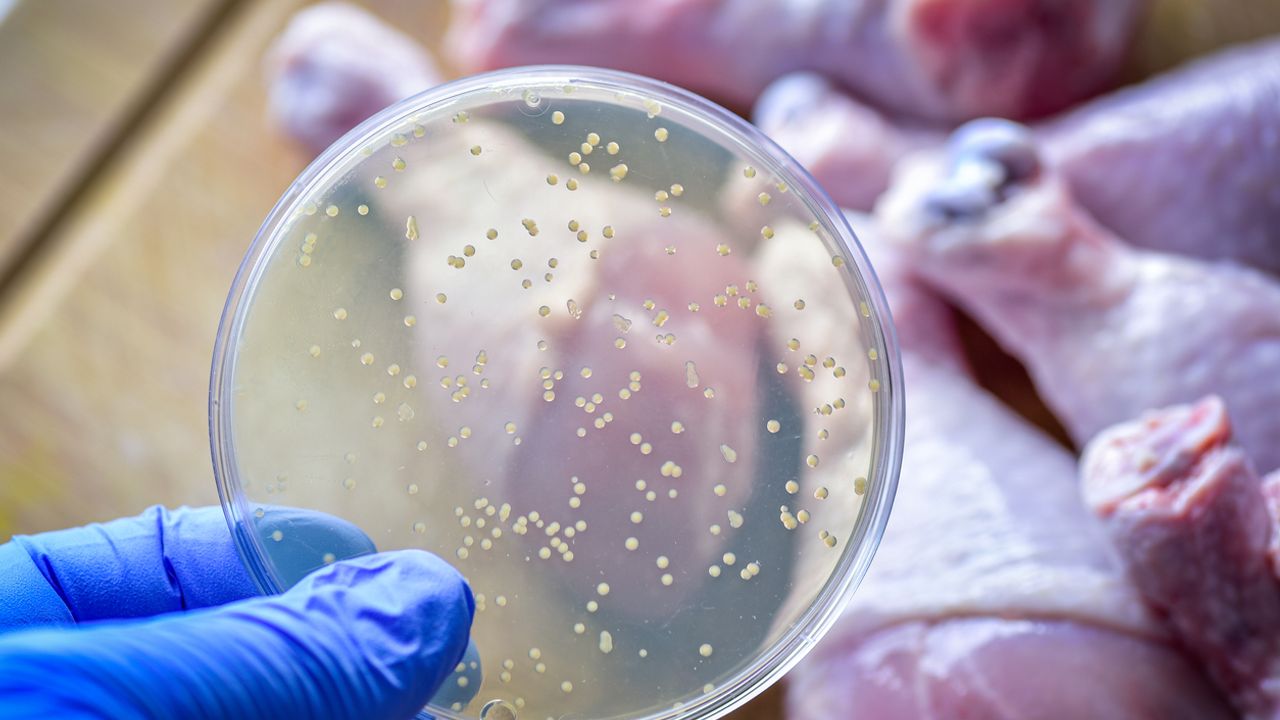

Son Mühür- İstanbul Eyüpsultan Topçular Mahallesi’nde yaşayan Yücel ve Aleyna Birkent çifti, çocukları Alparslan ve Melisa Rabia ile 22 Eylül’de yedikleri yemeğin ardından zehirlenme şüphesiyle hastaneye başvurdu. Kontroller sırasında anne Aleyna Birkent’in kalp krizi geçirdiği belirlendi ve tedavi altına alındı. Baba ile çocukları ise tedavilerinin ardından taburcu edildi.
Ertesi gün sabah saatlerinde çocukların yeniden rahatsızlanması üzerine Yücel Birkent, onları tekrar hastaneye götürdü. Ancak yapılan tüm müdahalelere rağmen iki çocuk kurtarılamadı. Olayla ilgili soruşturma başlatıldı.
“Muhtemelen Salmonella”

Sentetik biyoloji uzmanı Doç. Dr. Urartu Şeker, yaşanan ölümlerin büyük olasılıkla Salmonella bakterisi ve sonrasında gelişen sepsis nedeniyle meydana geldiğini söyledi. Şeker, “Küçük yaşlarını da göz önüne alınca bu tür durumlar daha muhtemel” dedi.
Şeker ayrıca Türkiye’de ekonomik sebeplerle tavuk tüketiminin olağanüstü arttığını hatırlatarak, ABD Hastalık Kontrol ve Önleme Merkezi (CDC) verilerine göre her 25 paket tavuktan birinde mikrobiyal bulaş tespit edildiğini aktardı.
Doç. Dr. Şeker, kanatlı hayvanların doğal olarak Salmonella taşıyıcısı olduğunu, etin doğru işlenmemesi ve pişirilmemesi durumunda bakterinin bulaşmasının şaşırtıcı olmadığını belirtti.
Uzman, şu noktalara dikkat çekti:
-Salmonella bulaşmış tavuk eti kokmayabilir, bu nedenle mutlaka iyi pişirilmelidir.
-Kanat ve baget gibi kemikli bölümlerde pembe renk kalmamasına özellikle dikkat edilmelidir.
-Etin iyice pişmesi, enfeksiyon riskini en aza indirmek için kritik bir unsurdur.
Salmonella nedir?
Sağlık Bakanlığı’na göre Salmonella enfeksiyonu (salmonelloz), bağırsak yolunu etkileyen bakteriyel bir hastalıktır. Bakteri genellikle hayvan ve insan bağırsaklarında bulunur, dışkı yoluyla atılır ve en sık su veya yiyeceklerle bulaşır.
Enfeksiyonun belirtileri 12-72 saat içinde ortaya çıkar. İshal, ateş, bulantı, kusma ve karın krampları yaygın şikayetler arasındadır. Hastalık genellikle 4-7 gün sürer. Ancak yaşlılar, bebekler ve bağışıklık sistemi zayıf olan kişilerde ağır seyredebilir ve hastane yatışı gerektirebilir.
İzmir’de bennzer bir vaka yaşanmıştı

Benzer bir olay 28 Aralık 2024’te İzmir Buca Efeler Mahallesi’nde yaşanmıştı. 60 yaşındaki Servet Polat, kızı ve torunuyla birlikte bir işletmede kumpir yedikten sonra kusma ve ishal şikâyetleriyle hastaneye başvurmuş, iki gün sonra evinde ölü bulunmuştu.
Adli Tıp Kurumu raporunda Polat’ın ölüm nedeninin gıda zehirlenmesi olduğu belirtilmiş, Tarım ve Orman Bakanlığı İzmir Gıda Kontrol Laboratuvarı incelemelerinde kumpir örneğinde Salmonella bakterisi tespit edilmişti.